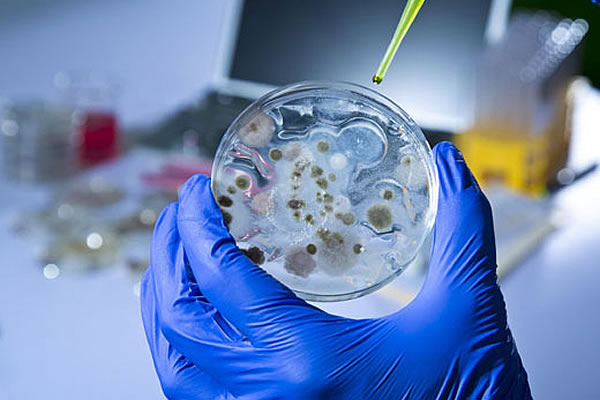

1. Glazba koja diže raspoloženje
Mnogim ženama glazba podigne raspoloženje, pogotovo za vrijeme predigre ili tijekom seksa. Birajte nešto senzualno i ritmično, a balade i tužaljke preskočite.
2. Bez pritiska
Požurivanje ili forsiranje u krevetu ženama je poput hladnog tuša, a i muškarcima.
– Čak i suptilni pritisak poput pitanja ‘Jesi li blizu? ili Hoćeš li’ mogu ju totalno isključiti – kaže Renée Hilliard, stručnjakinja za seks i veze.
3. Čekanje
Kao što smo već gore zaključili bilo bi dobro izbjeći bilo kakvu vrstu forsiranja. Uključujući i tempo. To znači da ne morate odmah u krevetu divljati poput životinje. Budite nježni i idite polako. Žena će vas sama zamoliti kada želi nešto ‘divlje’.
– Eksperimentirajte s različitim brzinama i dodirima. Masirajte ju, dodirujte, češkajte. Brže će se opustiti – savjetuje seks stručnjakinja.
4. Korištenje igračaka
Igračke su izvrsne za promjenu stvari, za maštanje i pružanje dodatne stimulacije.
5. Vrijeme i pažnja
Tijekom seksa posvetite pažnju partnerici. Ženama je uistinu potrebno 10 do 20 minuta da dosegnu orgazam, tako da strpljiv partner pomaže da dožive seksualno ispunjenje.
6. Nesebičnost
– Žene žele partnera koji stavlja njezine potrebe i zadovoljstvo na prvo mjesto – kaže stručnjakinja za spojeve Jaida Pervis te nadodaje kako je sjajna stvar imati nesebičnog partnera jer će vam htjeti uzvratiti zadovoljstvo pa je to win-win situacija.
7. Siguran prostor bez presude
– Seks nije uvijek savršen pa se tako mogu dogoditi neočekivani grčevi, mjesečnica, bolovi i slično – kaže klinički seksolog Cain Joyland.
Sve te nabrojene stvari su prilično česte i mogu biti neugodne, ali žene se žele osjećati sigurno tijekom seksa i znati da je sve što se dogodi u redu.
8. Raznolikost
Nitko ne želi cijelu noć voditi ljubav u jednom položaju. Novost je ono što uzbuđuje mozak, bilo da se radi o novom seksualnom položaju, igrački ili odjeći. Tyomi Morgan, certificirani seksolog, predlaže igranje više igara, eksperimentiranje s različitim spolnim položajima, spolne odnose na različitim mjestima u kući ili upotrebu igračke.
9. Obostrano oralno zadovoljstvo
Muškarci obožavaju kada ih žena zna oralno zadovoljiti, ali budite sigurni da je isto i kod žena. Strastveni entuzijazam kada ženi pružate oralni seks nikada nikoga nije povrijedio.
– Pitajte je više puta osjeća li se dobro i možete li što učiniti da to bude još bolje. Ako ne znate što radite, naučite – kaže Hilliard.
10. Maženje
Ponekad žena želi da ju zagrlite i tako spavate, a ponekad možda to i ne želi. Iako se ove preferencije mogu razlikovati ne samo od osobe do osobe, već i od situacije, najbolje je da se obratite svom partneru i pitate ih kako se trenutno osjećaju i za što su raspoloženi.
11. Otvoreni um
Možda želite unijeti igračke u vaš krevet ili želite isprobati novu pozu. Bitno je da o svemu pričate sa svojim partnerom.
12. Vokalni entuzijazam
Ne postoji ništa ljepše od partnera kojem je jednostavno stalo biti s vama i ne može vam prestati govoriti koliko ste prekrasni i koliko ga uzbuđujete. Recite uvijek ono što osjećate. prenosi 24sata
13. Zaštita
Budite spremni na seks sa zaštitom, osim ako se prethodno ne dogovorite drugačije.
14. Orgazam
Seks ne bi smio završiti samo muškim orgazmom pogotovo ako ga žena još nije doživjela. Ako ćete biti previše iscrpljeni nakon svog orgazma, pobrinite se da je unaprijed zbrinuta.
15. Komunikacija
Jedna od bitnijih stvari u vezi i u krevetu. Bez komunikacije nema ničega.
16. Čist krevet
Stvarno je teško prepustiti se uživanju ako vidite da je posteljina prljava. Ne zaboravite, ovo je vrlo važna stavka.
17. Ponudite joj punjač
Ako će nakon seksa prespavati kod vas, pitajte je treba li joj punjač za mobitel. Ipak danas ne možemo živjeti bez njega.
18. Predigra
Nikako ne zaboravite na predigru i uzmite si vremena za nju. Budite pažljivi i nježni i nemojte je preskakati.
19. Skinite čarape
Molimo vas, skinite čarape prije seksa. Jednostavno je čudno vidjeti nekoga potpuno golog s čarapama na nogama. Osim toga, tada žene vole razmišljati ‘Možda mu smrde noge’, ‘možda ima ružna stopala’ i slično.
20. Realna očekivanja
Nemojte očekivati porno seks jer seks u stvarnom životu baš i nije takav, piše Cosmopolitan.